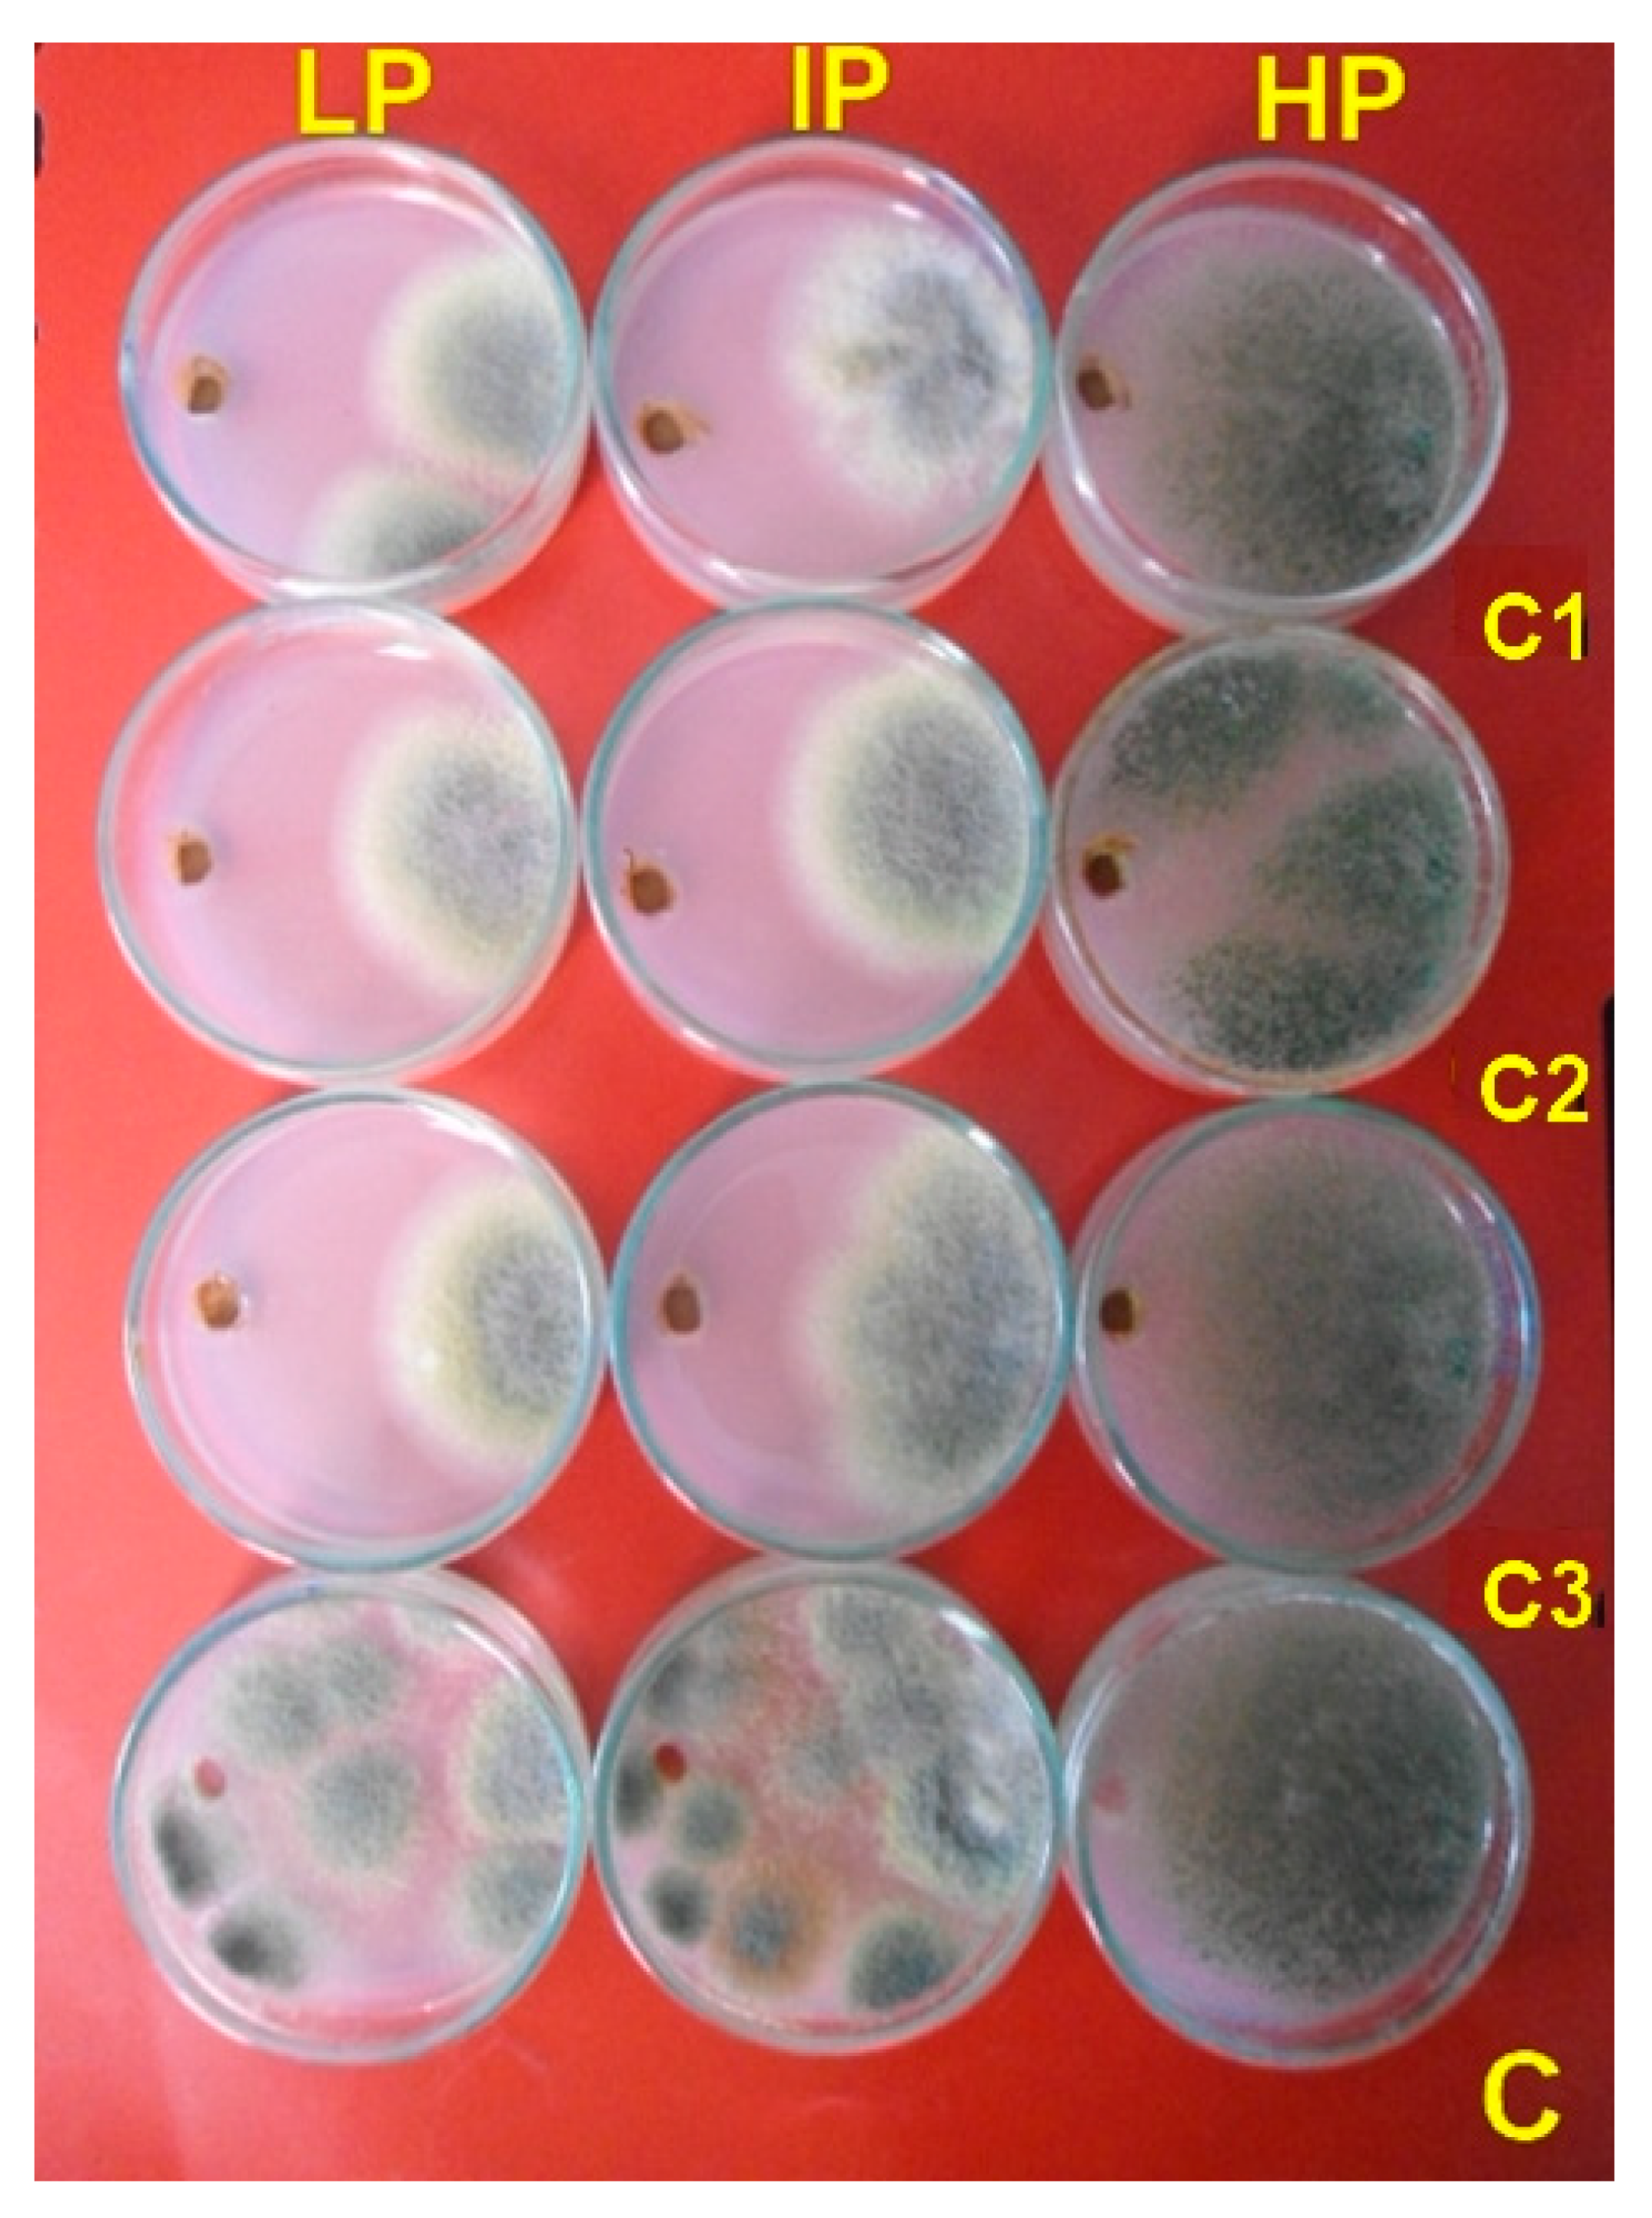

Silver/Chitosan Nanocomposites: Preparation and Characterization and Their Fungicidal Activity against Dairy Cattle Toxicosis Penicillium expansum
Abstract
1. Introduction
2. Materials and Methods
2.1. Synthesis and Characterization of Ag NPs-Chitosan Nanocomposites
2.2. Experimental Procedure
2.3. X-Ray Fluorescence Analysis (XRF)
2.4. Small-Angle Spread (SAXS)
2.5. X-Ray Photoelectron Spectroscopy (XPS)
2.6. Transmission Electron Microscope (TEM)
2.7. Pencillium Identification
2.8. Patulin- and Citrinin-Producing Ability
2.9. Screening for Antifungal Activity
2.10. Protein Degradation Test
2.11. Binding/Degradation of Genomic Fungal DNA
2.12. Scanning Electron Microscopy (SEM)
2.13. Statistical Analyses
3. Results
3.1. Physico-Chemical Characterization of Silver/Chitosan Nanocomposites
3.2. Analysis of Toxins for Patulin and Citrinin
3.3. Antifungal Activity
3.4. Characterize Nanocomposites-Fungal Protein Interactions
3.5. Analysis of the Binding/Degradation of Fungal Genomic DNA
3.6. Fungal Morphology Observation
4. Discussion
5. Conclusions
Author Contributions
Funding
Acknowledgments
Conflicts of Interest
References
- Raper, K.B.; Thom, C. A Manual of the Penicillia; Williams and Wilkins: Baltimore, MA, USA, 1949. [Google Scholar]
- Mansfield, M.A.; Jones, A.D.; Kuldau, G.A. Contamination of fresh and ensiled maize by multiple Penicillium mycotoxins. Phytopathology 2008, 98, 330–336. [Google Scholar] [CrossRef] [PubMed]
- Tangni, E.K.; Wambacq, E.; Bastiaanse, H.; Haesaert, G.; Pussemier, L.; De Poorter, J.; Foucart, G.; Van Hove, F. Survey of fungal diversity in silages supplied to dairy cattle in Belgium over a two-year period. J. Anim. Sci. Adv. 2017, 7, 1861–1873. [Google Scholar]
- Pleadin, J.; Frece, J.; Markov, K. Mycotoxins in food and feed. Adv. Food Nutr. Res. 2019, 89, 297–345. [Google Scholar]
- Greco, M.; Pardo, A.; Pose, G. Mycotoxigenic fungi and natural co-occurrence of mycotoxins in rainbow trout (Oncorhynchus mykiss) feeds. Toxins 2015, 7, 4594–4609. [Google Scholar] [CrossRef] [PubMed]
- Gupta, N.; Upadhyaya, C.P.; Singh, A.; Abd-Elsalam, K.A.; Prasad, R. Applications of silver nanoparticles in plant protection. In Nanobiotechnology Applications in Plant Protection; Springer International Publishing: Berlin, Germany, 2018; pp. 247–265. [Google Scholar]
- Abd-Elsalam, K.A.; Hashim, A.; Alghuthaymi, M.A.; Bahkali, A.H. Nanobiotechnological strategies for molud and mycotoxin control. In Nanotechnology in Food Industry, Volume VI: Food Preservation; Grumezescu, A.M., Ed.; ELSEVIER: Amsterdam, The Netherlands, 2016; pp. 337–364. [Google Scholar]
- Abd-Elsalam, K.A.; Prasad, R. Nanobiotechnology Applications in Plant Protection; Springer: Berlin, Germany, 2018; Available online: https://www.springer.com/gp/book/9783319911601 (accessed on 19 April 2020).
- Petica, A.; Gavriliu, S.; Lungu, M.; Buruntea, N.; Panzaru, C. Colloidal silver solutions with antimicrobial properties. Mater. Sci. Eng. B. 2008, 152, 22–27. [Google Scholar] [CrossRef]
- Egger, S.; Lehmann, R.P.; Height, M.J.; Loessner, M.J.; Schuppler, M. Antimicrobial properties of a novel silver-silica nanocomposite material. Appl. Environ. Microbiol. 2009, 75, 2973–2976. [Google Scholar] [CrossRef]
- Kasprowicz, M.J.; Kozioł, M.; Gorczyca, A. The effect of silver nanoparticles on phytopathogenic spores of Fusarium culmorum. Can. J. Microbiol. 2010, 56, 247–253. [Google Scholar] [CrossRef]
- Kasprowicz, M.J.; Gorczyca, A.; Frandsen, R.J.N. The effect of nanosilver on pigments production by Fusarium culmorum (WG Sm.) Sacc. Polish, J. Microbiol. 2013, 62, 365–372. [Google Scholar] [CrossRef]
- Jeong, S.H.; Hwnag, Y.H.; Yi, S.C. Antibacterial properties of padded PP/PE nonwovens incorporating nano-sized silver colloids. J. Mater. Sci. 2005, 40, 5413–5418. [Google Scholar] [CrossRef]
- Korbekandi, H.; Asghari, G.; Jalayer, S.S.; Jalayer, M.S.; Bandegani, M. Nanosilver particles production using Juglans regia (L. walnut) leaf extract. J. Nat. Pharm. Prod. 2013, 8, 20–26. [Google Scholar]
- Pulit, J.; Banach, M.; Szczygłowska, R.; Bryk, M. Nanosilver against fungi: Silver nanoparticles as an effective biocidal factor. Acta Biochem. Pol. 2013, 60, 795–798. [Google Scholar] [CrossRef]
- Kaur, P.; Thakur, R.; Choudhary, A. An in vitro study of the antifungal growth of silver/chitosan nanoformulations against important seed borne pathogens. Int. J. Sci. Technol. Res. 2012, 1, 83–86. [Google Scholar]
- Mathew, T.; Kuriakose, S. Photochemical and antimicrobial properties of silver nanoparticle-encapsulated chitosan functionalized with photoactive groups. Mater. Sci. Eng. C. 2013, 33, 4409–4415. [Google Scholar] [CrossRef] [PubMed]
- Chowdappa, P.; Shivakumar, C.; Chethana, S.; Madhura, S. Antifungal activity of chitosan-silver nanoparticles composite against Colletotrichum gloeosporioides associated with mango anthracnose. Afr. J. Microbiol. Res. 2014, 81, 1803–1812. [Google Scholar]
- Ismaiel, A.A.; Tharwat, N.A. Antifungal activity of silver ion on ultrastructure and production of aflatoxin B1 and patulin by two mycotoxigenic strains, Aspergillus flavus OC1 and Penicillium vulpinum CM1. J. Med. Mycol. 2014, 24, 193–204. [Google Scholar] [CrossRef]
- Rai, M.; Abd-Elsalam, K.A. Nanomycotoxicology Treating Mycotoxins in Nano Way, 1st ed.; Academic Press: Amsterdam, The Netherlands, 2019; p. 450. Available online: https://www.elsevier.com/books/nanomycotoxicology/rai/978-0-12-817998-7 (accessed on 19 April 2020).
- Jung, J.; Kasi, G.; Seo, J. Development of functional antimicrobial papers using chitosan/starch-silver nanoparticles. Int. J. Biol. Macromol. 2018, 112, 530–536. [Google Scholar] [CrossRef] [PubMed]
- Said-Galiev, E.E.; Vasil’kov, A.Y.; Nikolaev, A.Y.; Lisitsyn, A.I.; Naumkin, A.V.; Volkov, I.O.; Abramchuk, S.S.; Lependina, O.L.; Khokhlov, A.R.; Shtykova, E.V.; et al. Structure of mono-and bimetallic heterogeneous catalysts based on noble metals obtained by means of fluid technology and metal-vapor synthesis. Russ. J. Phys. Chem. A 2012, 86, 1602–1608. [Google Scholar] [CrossRef]
- Svergun, D.I. Determination of the regnlarization parameter in indirect-transform methods using perceptual criteria. J. Appl. Cryst. 1992, 25, 95–503. [Google Scholar] [CrossRef]
- Said-Galiev, E.E.; Gamzazade, A.I.; Grigor’ev, T.E.; Khokhlov, A.R.; Bakuleva, N.P.; Lyutova, I.G.; Shtykova, E.V.; Dembo, K.A.; Volkov, V.V. Synthesis of Ag and Cu-chitosan metal-polymer nanocomposites in supercritical carbon dioxide medium and study of their structure and antimicrobial activity. Nanotechnol. Russ. 2011, 6, 341–352. [Google Scholar] [CrossRef]
- Visagie, C.M.; Houbraken, J.; Frisvad, J.C.; Hong, S.B.; Klaassen, C.H.W.; Perrone, G.; Seifert, K.A.; Varga, J.; Yaguchi, T.; Samson, R.A. Identification and nomenclature of the genus Penicillium. Stud. Mycol. 2014, 78, 343–371. [Google Scholar] [CrossRef] [PubMed]
- Christian, G. HPLC Tips and Tricks; Great Britain at the Iden Press: Oxford, UK, 1990; p. 608. [Google Scholar]
- Franco, C.M.; Fente, C.A.; Vazquez, B.; Cepada, A.; Lallaoui, L.; Prognon, P.; Mahuzier, G. Simple and sensitive high-performance liquid chromatography-fluorescence method for the determination of citrinin. J. Chromatogr. 1996, 723, 69–75. [Google Scholar] [CrossRef]
- Rubina, M.S.; Vasil’kov, A.Y.; Naumkin, A.V.; Shtykova, E.V.; Abramchuk, S.S.; Alghuthaymi, M.A.; Abd-Elsalam, K.A. Synthesis and characterization of chitosan-copper nanocomposites and their fungicidal activity against two sclerotia-forming plant pathogenic fungi. J. Nanostruct. Chem. 2017, 7, 249–258. [Google Scholar] [CrossRef]
- Laemmli, U.K. Cleavage of structural proteins during the assembly of the head of bacteriophage T4. Nature 1970, 227, 680–685. [Google Scholar] [CrossRef]
- Rabilloud, T.; Vuillard, L.; Gilly, C.; Lawrence, J.J. Silver-staining of proteins in polyacrylamide gels: A general overview. Cell. Mol. Biol. 1994, 40, 57–75. [Google Scholar] [PubMed]
- Moslem, M.; Abd-Elsalam, K.; Yassin, M.; Bahkali, A. First morphomolecular identification of Penicillium griseofulvum and Penicillium aurantiogriseum toxicogenic isolates associated with blue mold on apple. Foodborne Pathog. Dis. 2010, 7, 857–861. [Google Scholar] [CrossRef] [PubMed]
- Wagner, C.D. Faraday Discuss. Chem. Soc. 1975, 60, 291–300. [Google Scholar]
- Fuggle, J.C.; Kallne, E.; Watso, L.M.; Fabian, D.J. Electronic structure of aluminum and aluminum-noble-metal alloys studied by soft-X-ray and X-ray photoelectron spectroscopies. Phys. Rev. B. 1977, 16, 750–761. [Google Scholar] [CrossRef]
- Gaarenstroom, S.W.; Winograd, N. Initial and final state effects in the ESCA spectra of cadmium and silver oxides. J. Chem. Phys. 1977, 67, 3500–3506. [Google Scholar] [CrossRef]
- Tjeng, L.H.; Meinders, M.B.J.; van Elp, J.; Ghijsen, J.; Sawatzky, G.A.; Johnson, R.L. Electronic Structure of Ag2O. Phys. Rev. B. 1990, 41, 3190–3199. [Google Scholar] [CrossRef]
- Kaushik, V.K. XPS core-level spectra and Auger parameters for some silver compounds. J. Electron. Spectrosc. Relat. Phenom. 1991, 56, 273–277. [Google Scholar] [CrossRef]
- Hoflund, G.B.; Weaver, J.F.; Epling, W.S. Ag2O XPS spectra. Surf. Sci Spectra 1994, 3, 157–162. [Google Scholar] [CrossRef]
- Moulder, J.F.; Stickle, W.F.; Sobol, P.E.; Bomben, K.D. Handbook of X-ray Photoelectron Spectroscopy; Perkin Elmer Corporation: Eden Prairie, MN, USA, 1995. [Google Scholar]
- Naumkin, A.V.; Kraut-Vass, A.; Gaarenstroom, S.W.; Powell, C.J. NIST X-ray Photoelectron Spectroscopy Database; Version 4.1; National Institute of Standards and Technology: Gaithersburg, MD, USA, 2012. Available online: http://srdata.nist.gov/xps/ (accessed on 19 April 2020).
- Seah, M.P. AES: Energy calibration of electron spectrometers, IV? A re-evaluation of the reference energies. J. Electron. Spectrosc. Relat. Phenom. 1998, 97, 235–241. [Google Scholar] [CrossRef]
- Waterhouse, G.I.N.; Bowmaker, G.A.; Metson, J.B. Oxidation of a polycrystalline silver foil by reaction with ozone. Appl. Surf. Sci. 2001, 183, 191–204. [Google Scholar] [CrossRef]
- Powell, C.J. Recommended Auger parameters for 42 elemental solids. J. Electron. Spectrosc. Relat. Phenom. 2012, 185, 1–3. [Google Scholar] [CrossRef]
- Samoilova, N.; Krayukhina, M.; Naumkin, A.; Yamskov, I. Eco-friendly preparation of a magnetic catalyst for glucose oxidation combining the properties of nanometal particles and specific enzyme. Monatsh. Chem. 2018, 149, 1179–1188. [Google Scholar] [CrossRef]
- Schön, G.; Tummavuori, J.; Lindström, B.; Enzell, C.R.; Enzell, C.R.; Swahn, C.-G. ESCA Studies of Ag, Ag2O and AgO. Acta Chem. Scand. 1973, 27, 2623–2633. [Google Scholar] [CrossRef]
- Abrunhosa, L.; Paterson, R.R.M.; Kozakiewicz, Z.; Lima, N.; Venancio, A. Mycotoxin production from fungi isolated from grapes. Lett. Appl. Microbiol. 2001, 32, 240–242. [Google Scholar] [CrossRef]
- Bragulat, M.R.; Abarca, M.L.; Cabañes, F.J. Low occurrence of patulin- and citrinin-producing species isolated from grapes. Lett. Appl. Microbiol. 2008, 47, 286–289. [Google Scholar] [CrossRef]
- Tancinova, D.; Felsöciova, S.; Rybarik, L.; Maskova, Z.; Cisarova, M. Colonization of grapes berries and cider by potential producers of patulin. Potravinarstvo Slovak J. Food Sci. 2015, 9, 138–142. [Google Scholar]
- Ostry, V.; Malir, F.; Cumova, M.; Kyrova, V.; Toman, J.; Grosse, Y.; Pospichalova, M.; Ruprich, J. Investigation of patulin and citrinin in grape must and wine from grapes naturally contaminated by strains of Penicillium expansum. Food Chem. Toxicol. 2018, 118, 805–811. [Google Scholar] [CrossRef]
- Kim, J.S.; Kuk, E.; Yu, K.N.; Kim, J.H.; Park, S.J.; Lee, H.J.; Kim, S.H.; Park, Y.K.; Park, Y.H.; Hwang, C.Y.; et al. Antimicrobial effects of silver nanoparticles. Nanomed. Nanotechnol. Biol. Med. 2007, 3, 95–101. [Google Scholar] [CrossRef] [PubMed]
- Dibrov, P.; Dzioba, J.; Gosink, K.K.; Hase, C.C. Chemiosmotic mechanism of antimicrobial activity of Ag(þ) in Vibrio cholerae. Antimicrob. Agents Chemother 2002, 46, 2668–26670. [Google Scholar] [CrossRef] [PubMed]
- Raffi, M.; Hussain, F.; Bhatti, T.M.; Akhter, J.I.; Hameed, A.; Hasan, M.M. Antibacterial characterization of silver nanoparticles against E. coli ATCC-15224. J. Mater. Sci. Technol. 2008, 24, 192–196. [Google Scholar]
- Kim, J.; Lee, J.; Kwon, S.; Jeong, S. Preparation of biodegradable polymer/silver nanoparticles composite and its antibacterial efficacy. J. Nanosci. Nanotechnol. 2009, 9, 1098–1102. [Google Scholar] [CrossRef] [PubMed]
- Li, M.; Chen, C.; Xia, X.; Garba, B.; Shang, L.; Wang, Y. Proteomic analysis of the inhibitory effect of chitosan on Penicillium expansum. Food Sci. Technol. 2019. [Google Scholar] [CrossRef]
- Xia, Z.K.; Ma, Q.H.; Li, S.Y.; Zhang, D.Q.; Cong, L.; Tian, Y.L.; Yang, R.Y. The antifungal effect of silver nanoparticles on Trichosporon asahii. J. Microbiol.; Immunol. Infect. 2016, 49, 182–188. [Google Scholar] [CrossRef]
- Du, H.; Lo, T.M.; Sitompul, J.; Chang, M.W. Systems-level analysis of Escherichia coli response to silver nanoparticles: The roles of anaerobic respiration in microbial resistance. Biochem. Biophys. Res. Commun. 2012, 424, 657–662. [Google Scholar] [CrossRef]
- Arokiyaraj, S.; Choi, S.H.; Lee, Y.; Bharanidharan, R.; Hairul-Islam, V.I.; Vijayakumar, B.; Oh, Y.K.; Dinesh-Kumar, V.; Vincent, S.; Kim, K.H. Characterization of ambrette seed oil and its mode of action in bacteria. Molecules 2015, 20, 384–395. [Google Scholar] [CrossRef]
- Carlson, C.; Hussain, S.M.; Schrand, A.M.; K. Braydich-Stolle, L.; Hess, K.L.; Jones, R.L.; Schlager, J.J. Unique cellular interaction of silver nanoparticles: Size-dependent generation of reactive oxygen species. J. Phys. Chem. B. 2008, 112, 13608–13619. [Google Scholar] [CrossRef]
- Calvo, P.; Remunan-Lopez, C.; Vila-Jato, J.L.; Alonso, M.J. Novel hydrophilic chitosan-polyethylene oxide nanoparticles as protein carriers. J. Appl. Polym. Sci. 1997, 63, 125–132. [Google Scholar] [CrossRef]
- Kalagatur, N.K.; Ghosh, N.; Sivaraman, O.; Sundararaj, N. Antifungal activity of chitosan nanoparticles encapsulated with Cymbopogon martinii essential oil on plant pathogenic fungi Fusarium graminearum. Front. Pharmacol. 2018, 9, 610. [Google Scholar] [CrossRef] [PubMed]
- Márquez, I.G.; Akuaku, J.; Cruz, I.; Cheetham, J.; Golshani, A.; Smith, M.L. Disruption of protein synthesis as antifungal mode of action by chitosan. Int. J. Food Microbiol. 2013, 164, 108–112. [Google Scholar] [CrossRef] [PubMed]
- Mostafa, M.; Almmoamr, H.; Abd-Elsalam, K.A. Nanoantimicrobials Mechanism of Action. In Nanobiotechnology Applications in Plant Protection; Abd-Elsalam, K., Prasad, R., Eds.; Springer: Berlin/Heidelberg, Germany, 2018. [Google Scholar]
- Abdel-Hafez, S.I.; Nafady, N.A.; Abdel-Rahim, I.R.; Shaltout, A.M.; Daròs, J.A.; Mohamed, M.A. Assessment of protein silver nanoparticles toxicity against pathogenic Alternaria solani. 3 Biotech. 2016, 6, 199. [Google Scholar] [CrossRef] [PubMed]
- Oliveira Junior, E.N.D.; Melo, I.S.D.; Franco, T.T. Changes in hyphal morphology due to chitosan treatment in some fungal species. Brazil. Archiv. Biol. Technol. 2012, 55, 637–646. [Google Scholar] [CrossRef]

| Sample | C | O | Ag | Si | Zn | N | Cl | F |
|---|---|---|---|---|---|---|---|---|
| 1 | 66.38 | 24.38 | 1.25 | 4.06 | 0.22 | 3.70 | - | - |
| 2 | 59.43 | 27.72 | - | 3.71 | 0.51 | 4.93 | 0.14 | 3.56 |
| Isolate Code | Pencillium Species | Feed Source | Mycotoxin Concentration (ppb) | |
|---|---|---|---|---|
| Patulin | Citrinin | |||
| 1. | Penicillium paneum | maize silages | 37.40 | ND |
| 2. | Penicillium paneum | maize silages | 91.10 | ND |
| 3. | Penicillium paneum | maize silages | 80.36 | ND |
| 4. | Penicillium expansum | cottonseed meals | 0.00 | 40.19 |
| 5. | Penicillium expansum | maize silages | 13.90 | 11.70 |
| 6. | Penicillium expansum | maize silages | 44.50 | 50.63 |
| 7. | Penicillium expansum * | maize silages | 83.14 | 72.20 |
| 8. | Penicillium citrinum | maize-Bran | ND | 120.0 |
| 9. | Penicillium citrinum | dry natural forage | ND | 88.56 |
| 10. | Penicillium citrinum | dry natural forage | ND | 197.20 |
| 11. | Penicillium citrinum | sunflower oilcake | ND | 77.13 |
| 12. | Penicillium citrinum | maize silages | ND | 0.0 |
| 13. | Penicillium citrinum | dry natural forage | ND | 60.22 |
| 14. | Penicillium griseofulvum | dry natural forage | 67.50 | ND |
| 15. | Penicillium verrucosum | maize silages | ND | 97.18 |
| 16. | Penicillium verrucosum | maize silages | ND | 143.0 |
| 17. | Penicillium verrucosum | maize silages | ND | 24.00 |
| Concentrations (mg·mL−1) | Penicillium expansum Strains | |||
|---|---|---|---|---|
| LP | IP | HP | Mean | |
| 0.30 | 3.16 | 3.48 | 2.50 | 3.16 |
| 0.60 | 3.66 | 3.56 | 2.45 | 3.66 |
| 0.90 | 3.79 | 3.82 | 2.39 | 3.79 |
| Control | 0.00 | 0.00 | 0.00 | 0.00 |
| LSD (p < 0.05) | 0.363 | 0.234 | 0.220 | - |
© 2020 by the authors. Licensee MDPI, Basel, Switzerland. This article is an open access article distributed under the terms and conditions of the Creative Commons Attribution (CC BY) license (http://creativecommons.org/licenses/by/4.0/).
Share and Cite
Alghuthaymi, M.A.; Abd-Elsalam, K.A.; Shami, A.; Said-Galive, E.; Shtykova, E.V.; Naumkin, A.V. Silver/Chitosan Nanocomposites: Preparation and Characterization and Their Fungicidal Activity against Dairy Cattle Toxicosis Penicillium expansum. J. Fungi 2020, 6, 51. https://doi.org/10.3390/jof6020051
Alghuthaymi MA, Abd-Elsalam KA, Shami A, Said-Galive E, Shtykova EV, Naumkin AV. Silver/Chitosan Nanocomposites: Preparation and Characterization and Their Fungicidal Activity against Dairy Cattle Toxicosis Penicillium expansum. Journal of Fungi. 2020; 6(2):51. https://doi.org/10.3390/jof6020051
Chicago/Turabian StyleAlghuthaymi, Mousa A., Kamel A. Abd-Elsalam, Ashwag Shami, Ernest Said-Galive, Eleonora V. Shtykova, and Alexander V. Naumkin. 2020. "Silver/Chitosan Nanocomposites: Preparation and Characterization and Their Fungicidal Activity against Dairy Cattle Toxicosis Penicillium expansum" Journal of Fungi 6, no. 2: 51. https://doi.org/10.3390/jof6020051
APA StyleAlghuthaymi, M. A., Abd-Elsalam, K. A., Shami, A., Said-Galive, E., Shtykova, E. V., & Naumkin, A. V. (2020). Silver/Chitosan Nanocomposites: Preparation and Characterization and Their Fungicidal Activity against Dairy Cattle Toxicosis Penicillium expansum. Journal of Fungi, 6(2), 51. https://doi.org/10.3390/jof6020051

